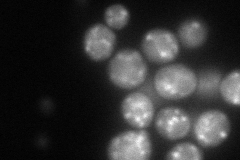
YDR367W
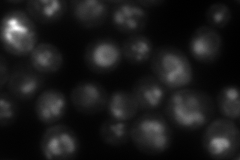
YDR367W
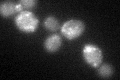
YDR367W
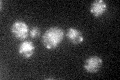
YDR367W

View description
Component of inositol phosphorylceramide (IPC) synthase; forms a complex with Aur1p and regulates its activity; required for IPC synthase complex localization to the Golgi; post-translationally processed by Kex2p; KEI1 is an essential gene
Localization:
Intensity:
Fold change:
Significance:
-
C’ GFP library in SD

punctate46.47 -
N' NOP1pr-GFP in SD
punctate105.272 -
N' TEF2pr-mCherry in SD
cell periphery,vacuole269.276 -
N' NATIVEpr-GFP in SD

punctate42.567 -
N' TEF2pr-VC and Cyto-VN in SD

ER,punctate32.9841 -
C’ GFP library in SD+DTT
punctate34.910.75No -
C’ GFP library in SD+H2O2

punctate44.330.95No -
C’ GFP library in Starvation Media
punctate28.860.62Yes -
C’ GFP library on the background of Pup2-DaMP

punctate -
C’ GFP library on the background of CCT mutant

punctate47.33021.01839No
